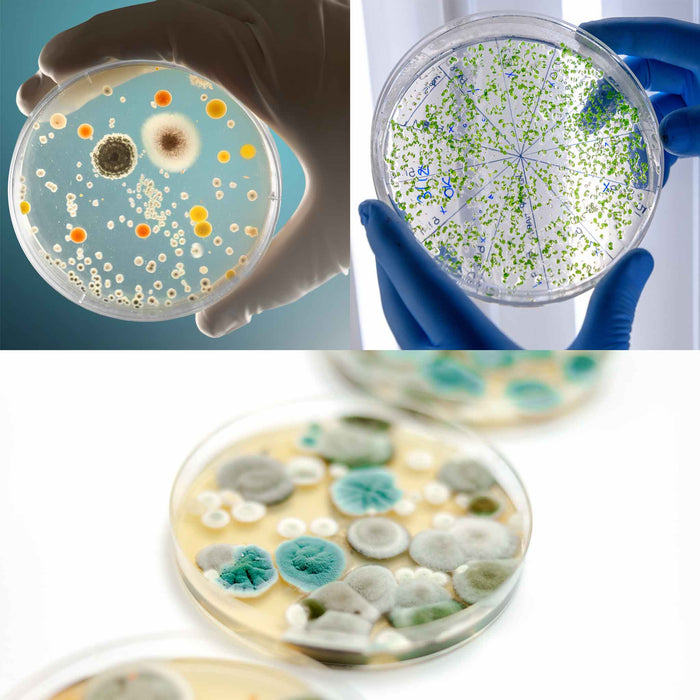
Bacteria Farm

SCIENCE MADE FUN: The Bacteria Farm is a great first biology kit for any budding scientist. You can cultivate and observe bacteria from different samples with a variety of experiments. Watch bacteria grow and live in a safe and controlled setting.
LEARN WITH GERMS: With this biology science kit, children will be learning about bacteria while performing 3 easy hands-on experiments. While learning about different types of bacteria, kids will be making a variety of cultures and growing "gross stuff." This kit is educational, fun, and makes children aware of the germs around them. Don't forget to wash your hands!
BUILDING YOUR BRAIN: Heebie Jeebies prides itself on creating kits, toys, gear, accessories, and more for science enthusiasts. Their products are a great way to put a smile on a scientist's face or to plant the seeds of science in a growing mind.
FUN FOR EVERYONE: Heebie Jeebies loves to create fun things for both big and little inquisitive minds. We design and develop many of our own products as well as sourcing the latest exciting products from around the world for the newest and coolest items on the market.
PRODUCT SPECIFICATIONS: Package contains (1) Heebie Jeebies Bacteria Farm - Ages 8+. 3 easy hands-on experiments. Educational, fun, and makes children aware of the germs around them. Full color animated activity guide included!
LEARN WITH GERMS: With this biology science kit, children will be learning about bacteria while performing 3 easy hands-on experiments. While learning about different types of bacteria, kids will be making a variety of cultures and growing "gross stuff." This kit is educational, fun, and makes children aware of the germs around them. Don't forget to wash your hands!
BUILDING YOUR BRAIN: Heebie Jeebies prides itself on creating kits, toys, gear, accessories, and more for science enthusiasts. Their products are a great way to put a smile on a scientist's face or to plant the seeds of science in a growing mind.
FUN FOR EVERYONE: Heebie Jeebies loves to create fun things for both big and little inquisitive minds. We design and develop many of our own products as well as sourcing the latest exciting products from around the world for the newest and coolest items on the market.
PRODUCT SPECIFICATIONS: Package contains (1) Heebie Jeebies Bacteria Farm - Ages 8+. 3 easy hands-on experiments. Educational, fun, and makes children aware of the germs around them. Full color animated activity guide included!